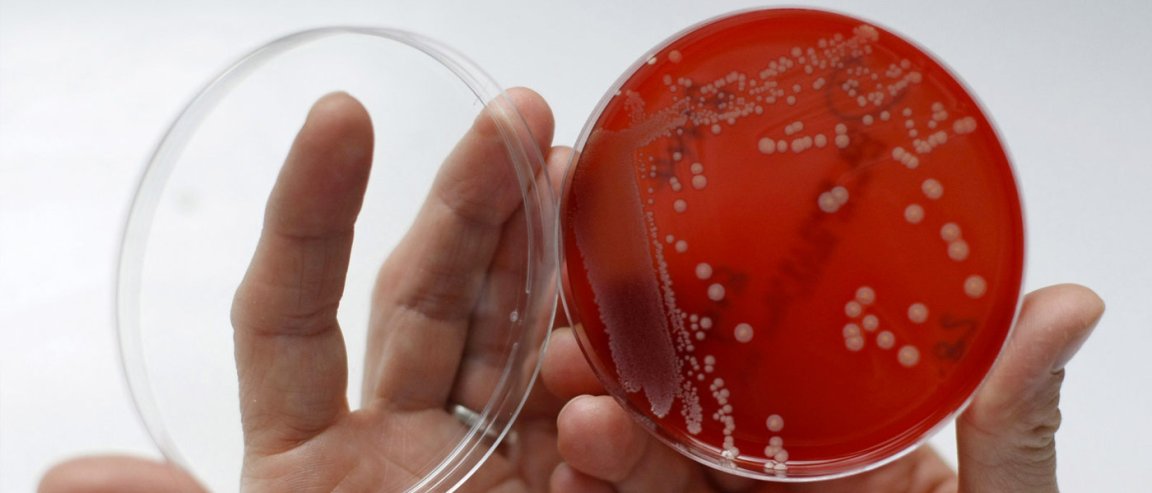

Artificial Solutions
Superbugs are a pressing concern in healthcare. The issue of drug-resistant bacteria is so large that even the UN General Assembly is meeting just to discuss this pressing threat.
Researchers may have found a new avenue toward defeating these superbugs. Two different research teams have engineered artificial molecules that can destroy these resistant bacteria, or at the very least, make them susceptible to modern antibiotics again.
One of the teams, based at the University of Melbourne, have created “peptide polymers”, star-shaped bacteria made of short protein chains. These can kill bacteria using multiple pathways, unlike regular drug which are only “single pathway.”

The superbugs register no resistance to the star-shaped killers. Furthermore, these peptide polymers are completely safe, requiring 100x the regular dosage to kill red blood cells.
The other research comes from UT Southwestern Medical Center. The have created a synthetic compound that removes a primary defense bacteria have against antibiotics.
The researchers were playing with peptide-conjugated phosphorodiamidate morpholino oligomers or PPMOs. They engineered PPMOs to target a specific “efflux-pump complex,” AcrAB-TolC, which gives bacteria the ability to expel antibiotics that enter its body.
By preventing the creation of the AcrAB protein, bacteria again become susceptible to attack from antibiotics. In fact, antibiotics which were previously ineffective to regular bacteria became deadly, when used in conjunction with the PPMO compound.
Further Development
This kind of new research provides doctors with new tools in order to combat superbugs. Currently, we are at the bottom of the barrel when medicine is prescribed, since bacteria are developing resistance even to “last-resort” drugs.
But we are certainly not in the clear just yet. More research is required to ensure this method is as effective on all microbes. Human trials are also an important next step to prove the validity of the synthetic molecules. The only way to move forward is to further research in how to keep up the fight with these superpowered bacteria. We may have created superbugs, but with a continued focus on science and technology, we can ensure we find ways of beating them.